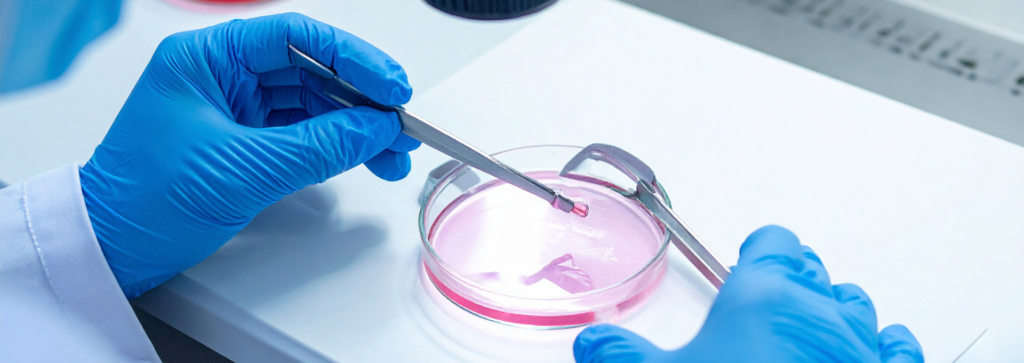

If you are reading this page, chances are you have already been through a lot. Months of trying naturally, maybe a few failed IUI cycles, maybe conflicting opinions from different doctors. And now you are seriously considering IVF treatment in Wakad but want real answers before committing to anything.
This page is going to give you exactly that. No fluff. No vague promises. Just a clear, honest breakdown of how IVF works under Dr. Pavan Bendale, what the process looks like from day one, how much it actually costs, and why couples from across Wakad, Tathawade, Hinjewadi, and Pimpri-Chinchwad are choosing him for their IVF cycle.
So, How Does an IVF Cycle Actually Work?
IVF stands for In-Vitro Fertilization. In plain language, it means your eggs are collected, fertilized with sperm in a lab, and the healthiest embryo is placed back into your uterus. Simple concept. But the execution has to be precise.

Here is what a single IVF cycle looks like under Dr. Pavan Bendale, broken down into the actual steps you will go through:
1. Ovarian Stimulation (Day 1 to Day 12-14)
You start with hormone injections that tell your ovaries to produce multiple eggs instead of just one. These are small subcutaneous injections, not as scary as they sound. Dr. Pavan Bendale customizes the medication type and dosage based on your AMH, age, weight, and how your body has responded to hormones in the past. There is no standard protocol applied to everyone here.
2. Follicle Monitoring (Every 2-3 Days)
Ultrasound scans track your follicle growth. Blood work checks your estrogen and progesterone levels. This is where the fine-tuning happens. If a follicle is growing too fast or too slow, medication gets adjusted the same day.
3. Trigger Shot and Egg Retrieval
Once your follicles hit the right size (usually 18-20mm), you get a trigger injection. About 34 to 36 hours later, eggs are retrieved through a short procedure under sedation. It takes roughly 20 minutes. You walk out the same day.
4. Fertilization
Your eggs meet sperm in the lab. If there is a male factor issue like low count, poor motility, or high DNA fragmentation, ICSI is used instead of conventional IVF. In ICSI, a single healthy sperm is picked and injected directly into the egg. Both procedures happen in Dr. Pavan Bendale’s in-house embryology lab, which means your eggs and embryos never leave the building.
5. Embryo Culture (Day 1 to Day 5)
Fertilized eggs are monitored as they develop into embryos. When possible, embryos are grown to the blastocyst stage (Day 5), because blastocyst transfers tend to have higher implantation rates. If Preimplantation Genetic Testing (PGT) is needed, it happens at this stage.
6. Embryo Transfer
The best graded embryo is transferred into your uterus using a thin catheter. No anaesthesia required. The whole thing takes under 10 minutes and feels like a routine ultrasound.
7. The Two-Week Wait and Pregnancy Test
About 14 days after transfer, a beta-hCG blood test confirms whether implantation happened. This is the hardest part emotionally, and the team stays in touch throughout.
According to the Indian Council of Medical Research (ICMR), IVF success rates across India have improved significantly in the last decade thanks to better stimulation drugs, improved embryo culture media, and techniques like ICSI and blastocyst transfer.
Who Actually Needs IVF? And Who Does Not?
Here is something most websites will not tell you. Not everyone who walks through the door needs IVF. Some couples do perfectly well with timed intercourse or a simple IUI cycle. Dr. Pavan Bendale is very particular about this. If you do not need IVF, he will tell you that directly.
But IVF becomes the right call when you are dealing with any of the following:
1. Both fallopian tubes blocked or damaged beyond repair
2. Severe male infertility where natural fertilization is unlikely
3. PCOS that has not responded to ovulation induction or 2-3 IUI attempts
4. Endometriosis that is affecting your egg quality or tubal function
5. Unexplained infertility after multiple failed cycles of simpler treatments
6. Age above 35 where ovarian reserve is declining and time matters
7. Recurrent pregnancy loss that might benefit from genetic screening of embryos before transfer
8. Previous IVF failures at other centres where you want a fresh clinical opinion
If none of these apply, there might be a simpler, less expensive path. That gets discussed in your very first consultation.
Why Couples in Wakad Are Choosing Dr. Pavan Bendale Over Bigger Hospital Chains

There are plenty of IVF centres in Pune. Large corporate hospitals with fancy waiting rooms and heavy price tags. So why are patients from Wakad, Hinjewadi, Baner, Tathawade, and Pimpri-Chinchwad specifically coming to Dr. Pavan Bendale?
Here are the real reasons:
1. You deal with one doctor, start to finish.
Dr. Pavan Bendale handles your consultation, stimulation planning, scans, retrieval, transfer, and follow-up himself. There is no rotating roster of junior doctors who barely know your file. You are not patient number 47 in a batch. Your protocol is yours.
2. The embryology lab is in-house.
This matters more than most patients realize. When your eggs are retrieved, they go straight into the lab next door. No courier. No transport risk. No temperature fluctuations. Everything from fertilization to blastocyst culture happens in one controlled environment.
3. ICSI and PGT are available on-site.
If your case needs ICSI for male factor infertility, it is done here. If embryo genetic screening is recommended, PGT is performed before transfer. You do not get referred out for critical parts of your own cycle.
4. The pricing is transparent and EMI-friendly.
IVF treatment under Dr. Pavan Bendale starts at an EMI of just ₹9,999 per month. The cost of stimulation medications, monitoring, egg retrieval, lab charges, and embryo transfer is explained upfront. No surprise bills after the cycle is done.
5. It is 10 minutes from Hinjewadi IT Park.
For couples who work in the Hinjewadi-Wakad tech corridor, the location alone saves hours of commuting during a cycle when you need to visit every 2-3 days for monitoring.
“We tried at a big hospital first. Nobody explained anything properly. With Dr. Pavan Bendale, we finally understood what was happening with our body and why. That clarity made all the difference.”
— Verified patient, Google Reviews
Dr. Pavan Bendale vs. Typical IVF Centres in Pune: A Side-by-Side Look
| What Matters | Dr. Pavan Bendale | Most Other IVF Centres |
|---|---|---|
| Same doctor throughout your cycle | ✓ Yes | ✗ Rotating doctors |
| In-house embryology lab | ✓ On-site | ✗ Often outsourced |
| ICSI available in-house | ✓ Yes | ✗ Referred out |
| PGT (Genetic Embryo Testing) | ✓ Available | ✗ Not always offered |
| Individualized stimulation protocol | ✓ Custom per patient | ✗ Standard protocol |
| EMI / Affordable payment plans | ✓ From ₹9,999/month | ✗ Lump sum or limited |
| Transparent pricing (no hidden costs) | ✓ Full breakdown upfront | ✗ Surprise add-ons |
| Post-IVF pregnancy monitoring | ✓ Continued care | ✗ Discharged after transfer |
IVF Success Rates: What the Numbers Actually Mean
The IVF success rate under Dr. Pavan Bendale averages between 60 to 65 percent per cycle. That is above the national average.
But here is what you should understand about success rates. They are not a guarantee. They are a probability. And that probability shifts based on your age, your ovarian reserve, the quality of sperm, the specific diagnosis, and how your body responds to stimulation.
A 30-year-old woman with unexplained infertility and good AMH will have a very different success probability than a 40-year-old woman with diminished ovarian reserve. Dr. Pavan Bendale is upfront about these numbers during your consultation. You will never hear inflated statistics here.
What you will hear is a realistic, evidence-backed plan based on your specific situation. And with 2,000+ IVF babies delivered over the last decade, the clinical experience backing that plan is substantial.
What Does IVF Treatment in Wakad Actually Cost?
Straight answer. A single IVF cycle includes ovarian stimulation medications, follicle monitoring scans, egg retrieval under sedation, embryo culture, and embryo transfer.
Add-on procedures like ICSI, blastocyst culture, embryo freezing (vitrification), or PGT are separate and quoted clearly before your cycle begins. There are no hidden line items that show up after the fact.
EMI options starting at ₹9,999 per month are available for couples who need financial flexibility. Dr. Pavan Bendale’s belief is straightforward. Your bank balance should not decide whether you become a parent.
For an exact cost estimate based on your diagnosis, a consultation will give you a clear number.
IVF vs. ICSI: Do You Need Both?
This confuses a lot of couples, so here is the simple version.
In standard IVF, eggs and sperm are placed together in a dish and fertilization happens on its own. In ICSI, an embryologist selects one healthy sperm and injects it directly into the egg using a microneedle.
ICSI is recommended when:
a) The semen analysis shows low sperm count or poor motility
b) There is high DNA fragmentation in the sperm sample
c) Sperm is surgically retrieved through TESA or PESA
d) A previous IVF cycle showed poor or zero fertilization
Dr. Pavan Bendale reviews every couple’s semen analysis and clinical history before deciding whether conventional IVF or ICSI is the better approach. Both are performed in the same in-house lab by the same experienced embryology team.
The World Health Organization classifies infertility as a disease of the reproductive system, reinforcing why evidence-based treatments like IVF and ICSI are medically necessary interventions, not elective procedures.
Common Questions Couples Ask Before Starting IVF in Wakad
1. Is the IVF process painful?
The hormone injections are subcutaneous and feel like a small pinch. Egg retrieval is under sedation, so you will not feel it. Most patients say the anxiety before starting was worse than the actual experience.
2. How many cycles does it usually take?
A significant number of patients conceive in their first or second cycle. But this depends on your age, diagnosis, and embryo quality. Dr. Pavan Bendale discusses realistic timelines in your first sitting.
3. Can I do IVF if I have PCOS?
Yes, and often with very good results. PCOS patients tend to produce more eggs during stimulation, which can actually work in your favour when managed correctly. Modified protocols prevent overstimulation while maximizing egg quality.
4. Is there an age limit for IVF?
There is no strict cutoff, but success rates drop significantly after 40. If you are 35 or older, early consultation is strongly recommended so you are not losing months to indecision.
5. What if my first IVF cycle fails?
A failed cycle is not the end. Dr. Pavan Bendale reviews what happened, what can be improved, and whether a protocol change, PGT, or a different approach like donor eggs makes sense for the next attempt.
“After 3 years of trying and one failed cycle at another centre, we came to Dr. Pavan Bendale. He changed the protocol completely. We are now parents of a healthy baby girl. Forever grateful.”
— Verified patient, Google Reviews
Ready to Talk? Here Is How to Start.
You do not need to have all the answers before your first visit. You just need to show up.
Bring your previous reports if you have them. If you do not, that is fine too. The first consultation with Dr. Pavan Bendale is a proper clinical evaluation, not a sales pitch. You will leave with clarity on your diagnosis, your options, and a treatment plan that makes sense for your body and your budget.
Dr. Pavan Bendale
301, 3rd Floor, Darekar Heights, Dange Chowk Road, Bhumkar Chowk Rd, Opp. Pandit Petrol Pump, Tathawade, Pune 411033
Call / WhatsApp: 07840950737
Email: pavanbendale007@gmail.com
One consultation. Real answers. No pressure.